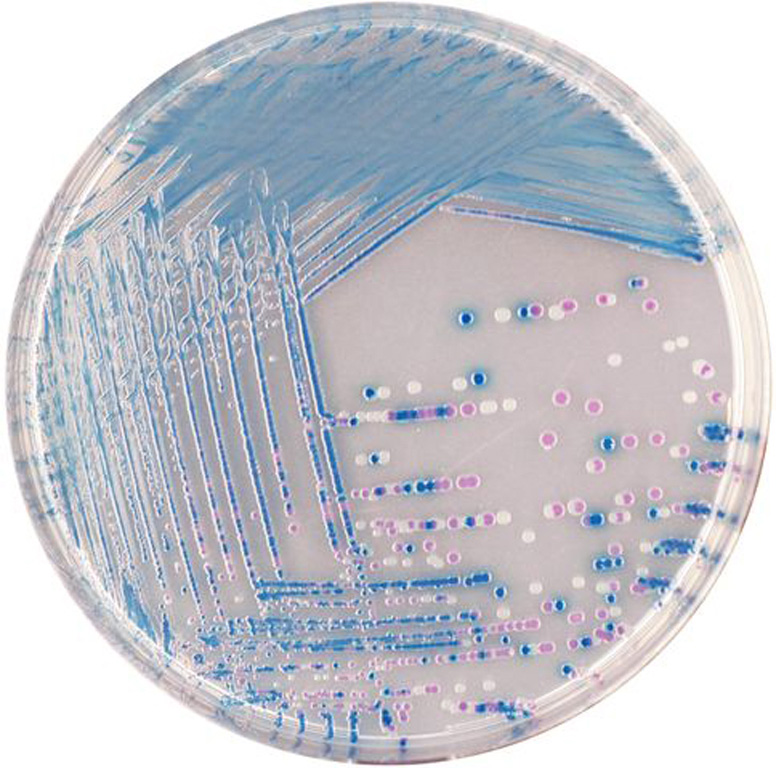

Über das Produkt
Chromogenes Medium zur selektiven Isolierung und Differenzierung von E. coli O157 in Lebensmittelproben.
Ähnliche Produkte
CHROMagar Enterobacteria Fertigplatten (ohne CE)
CHROMagar E.coli Fertigplatten (ohne CE)
CHROMagar STEC Fertigplatten